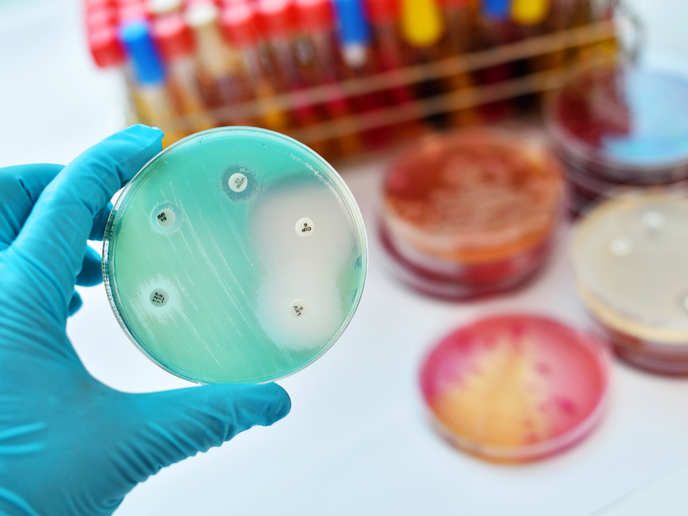

New insight into repression of antimicrobial resistance
Vancomycin is an antibiotic used in the clinic as a last-resort treatment for many life-threatening bacterial infections including those caused by methicillin-resistant Staphylococcus aureus (MRSA). However, vancomycin resistance (VR) has been reported in S. aureus and other important Enterococcus pathogens, giving rise to dangerous nosocomial infections. As with all AMR, VR is caused by gene clusters that are transferrable among different bacterial species.
Insight into the mechanism of VR repression
Recent evidence indicates that inorganic phosphate (Pi) induces hypersensitivity to vancomycin in resistant species that contain all the VR gene clusters, suggesting this nutrient plays a key role in VR repression. This urged the scientists of the Vanrestrep project to investigate the effect of the availability of Pi on the VR mechanism. The research was undertaken with the support of the Marie Skłodowska-Curie programme and employed the model Gram-positive bacterium Streptomyces coelicolor. “Our goal was to understand the repression of the VR mechanism in this resistant species,” explains the research fellow Fernando Santos-Beneit. Project members developed a gene-reporter expression tool to evaluate the conditions required for this repression in vivo and in vitro. They also employed genetic engineering strategies and next-generation sequencing (NGS) analysis to compare the genomes of specifically selected mutant strains. They discovered that S. coelicolor strains with mutations in the vanS gene can rescue resistance in media containing high Pi(opens in new window). VanS is a sensor protein located in the membrane; in combination with the transcriptional regulator VanR, it induces the genes responsible for VR in response to vancomycin. VR rescue was also observed in strains with mutations in the SCO2594 and SCO1213 genes, which encode enzymes that modulate the bacterial cell envelope. Changes in the charge of the bacterial cell envelope might enhance or diminish the non-specific binding of charged antibiotics, such as vancomycin, to the cell wall. “This observation points to the importance of the nutritional conditions of the culture media, which often determine the composition of the cell wall and the antibiotic resistance pattern of bacteria,” emphasises Santos-Beneit.
Project significance and prospects
Combating the growing problem of AMR has proved challenging. There is an active research field investigating compounds that interfere with resistance mechanisms and greatly prolong the use of existing drugs. Therefore, it is fundamental to delineate the mechanisms of AMR and how it is regulated. “Vanrestrep has shown that antibiotic resistance is a dynamic phenomenon and can be influenced by nutrition, urging us to revisit existing AMR testing protocols,” concludes Santos-Beneit. Indeed, the standard methods of antimicrobial susceptibility testing involve media that contain Pi, which may impact the final results. Therefore, new media compositions that allow reproducible and non-variable results in a wide range of nutritional conditions, antibiotic and pathogenic bacteria should be developed and patented. Towards this goal, Vanrestrep has been selected by the EU Innovation Radar(opens in new window) and go-to-market initiatives, to gain access to clients, investors and high-end coaching services to commercialise its findings.